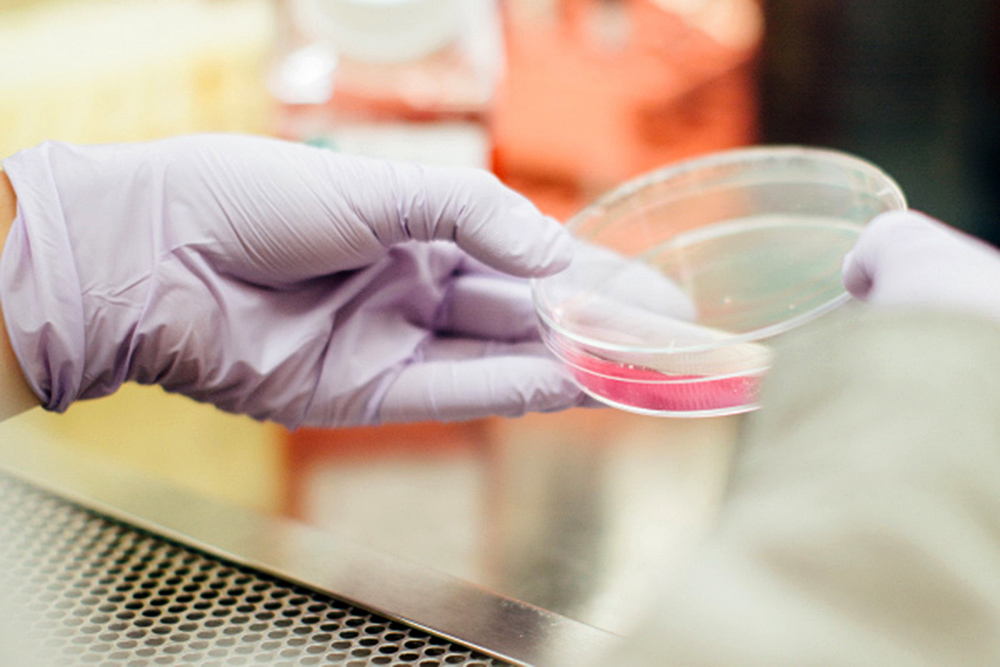

Científicos establecieron una relación entre el sistema digestivo y el cerebro al descubrir que la microbiota intestinal puede modular los síntomas de ELA
Científicos encontraron una relación entre la flora intestinal y el desarrollo de síntomas de esclerosis lateral amiotrófica (ELA), una enfermedad neurodegenerativa de tipo neuromuscular. Descubrieron que, en ratones con la misma mutación del gen C9orf72, vinculado a la enfermedad ELA, es posible prevenir o mejorar los síntomas de la enfermedad por medio de cambios en el microbioma intestinal o a través de trasplantes fecales.
Los investigadores realizaron estudios en ratones con una versión mutante del gen C9orf72 en dos laboratorios distintos y notaron que los ratones criados en Harvard tenían una respuesta inmune hiperactiva, con inflamación del sistema nervioso y el resto del cuerpo, como resultado una menor esperanza de vida. En contraste, los animales del Instituto Broad del InstitutoTecnológico de Massachusetts (MIT) y Harvard, aunque genéticamente idénticos, no presentaron muchos de estos síntomas inflamatorios e incluso sobrevivieron hasta la vejez.
Debido a las condiciones estandarizadas en los experimentos y laboratorios de ambas instituciones educativas, Aaron Burberry, asociado posdoctoral en el laboratorio Eggan, y el resto de los autores de esta investigación, comenzaron a descartar factores externos (como la dieta o los ciclos de luz), hasta encontrar que en la microbiota de los ratones de Harvard era más común un virus llamado norovirus murino así como las bacterias Helicobacter, Pasteurella pneumotropica y Tritrichomonas muris, lo cual relacionaron con la severidad de la enfermedad ELA en los especímenes de ese laboratorio.
A continuación, estudiaron el efecto de antibióticos y de trasplante de microbiota fecal en los síntomas inflamatorios de los ratones del laboratorio de Harvard. En ratones jóvenes, los antibióticos administrados impidieron la inducción de citocinas proinflamatorias y redujeron otras características distintivas de la inflamación conforme crecieron, efecto similar en especímenes adultos. Al realizar trasplantes de microbiota fecal de los roedores de Broad, los científicos observaron también un efecto desinflamatorio en los animales de Harvard.
Mediante esta investigación, Burberry y sus colegas han establecido una relación entre el sistema digestivo y el cerebro, al descubrir los efectos de la microbiota intestinal en los síntomas inflamatorios de la esclerosis lateral amiotrófica y cómo modulan la gravedad de la enfermedad. Esta información podría ser decisiva en la creación de nuevas terapias y explica también la razón de que sólo algunos individuos portadores de la mutación desarrollen la enfermedad. Futuros estudios aún deben indagar qué microbios en particular modulan la inflamación afuera del sistema nervioso central y cómo lo hacen.